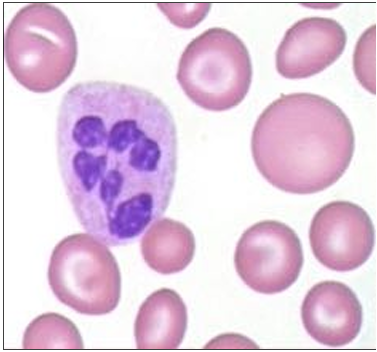
Enunciado 4578928-1

Foram encontradas 2.179 questões.
Uma jovem de 19 anos, altura 1,58 m e peso 51 kg, faz a sua primeira doação de sangue. Pouco antes de a coleta do sangue se completar, ela começa a suar e a ficar pálida, e diz estar tonta e com muito enjoo. A doação é interrompida, e se constata que a doadora apresenta hipotensão e bradicardia. Ela melhorou após ser colocada em posição de Trendelenburg.
Esse conjunto de sinais e sintomas é característico do seguinte tipo de reação adversa à doação de sangue:
Provas
O esfregaço sanguíneo é mostrado abaixo.
Diante do quadro descrito, o diagnóstico mais provável é:
Provas
O tratamento da hemorragia deve ser feito com:
Provas
• anti-HBc: positivo; • HBsAg: negativo; • HBV (NAT individual): negativo; • anti-HBsAg: positivo (> 10UI/mL).
Com esses resultados, é correto concluir que o doador:
Provas
Provas
• hemoglobina: 18,5 g/dL; • leucócitos: 10.500/µL; • plaquetas: 300.000/µL.
Para confirmar o diagnóstico de policitemia vera, é necessário:
Provas
Provas
Um paciente de 39 anos, sexo masculino, é submetido a alguns exames de rotina, em que foi encontrada uma dosagem de ferritina de 800 ng/dL. A dosagem de hemoglobina era de 15g/dL. Foi solicitada pesquisa das mutações genéticas C282Y, e H63D, cujos resultados foram:
• C282Y: positiva, em homozigose;
• H63D: positiva, em heterozigose.
Com esses resultados, o tratamento dessa condição deve ser feito com:
Provas
Diante desse quadro, a opção terapêutica para reverter rapidamente a discrasia sanguínea é:
Provas
O tratamento indicado para essa paciente é:
Provas
Caderno Container